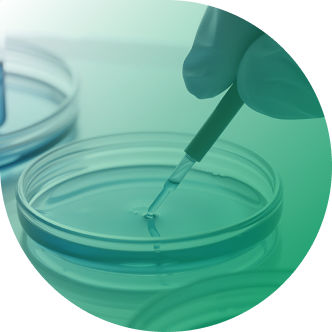

Rianlon's "three life curves"
Building a sustainable development model symbolized by
"rice in the pot, grain in the barn, and crops in the field" representing stability,resilience, and long-term growth.
-
 Rice in the pot–Anti-aging additives businessRice in the pot–Anti-aging additives business
Rice in the pot–Anti-aging additives businessRice in the pot–Anti-aging additives businessAfter over three decades of dedicated effort, Rianlon has become a leading global supplier of anti-aging products and technologies for polymer materials.
-
 Grain in the Barn–Lubricant Additives BusinessGrain in the Barn–Lubricant Additives Business
Grain in the Barn–Lubricant Additives BusinessGrain in the Barn–Lubricant Additives BusinessJinzhou Kangtai focuses on the R&D, production, sales, and service of lubricant additives, offering one of the most comprehensive product portfolios in China.
-
 Grain in the Barn–Personal Care BusinessGrain in the Barn–Personal Care Business
Grain in the Barn–Personal Care BusinessGrain in the Barn–Personal Care BusinessAegis, a leading global supplier in UV protection, specializes in high-quality sunscreens, UV enhancers, antioxidants, and active ingredient solutions.
-
 Crops in the Field –Biomanufacturing BusinessCrops in the Field –Biomanufacturing Business
Crops in the Field –Biomanufacturing BusinessCrops in the Field –Biomanufacturing BusinessThe Life Sciences Division covers two industrial directions: building blocks and synthetic biology, which are both independent and highly synergistic in business logic and industrial relevance.
-
 Crops in the Field – New Materials such as Polyimide (PI)Crops in the Field – New Materials such as Polyimide (PI)
Crops in the Field – New Materials such as Polyimide (PI)Crops in the Field – New Materials such as Polyimide (PI)Yixing Chuangju Electronic Materials Co., Ltd., a top-tier supplier of advanced polyimide films, fills gaps in product and technology for domestic electronic-grade PI materials.
-
 Rice in the pot–Anti-aging additives businessRice in the pot–Anti-aging additives business
Rice in the pot–Anti-aging additives businessRice in the pot–Anti-aging additives businessAfter over three decades of dedicated effort, Rianlon has become a leading global supplier of anti-aging products and technologies for polymer materials.
-
 Grain in the Barn–Lubricant Additives BusinessGrain in the Barn–Lubricant Additives Business
Grain in the Barn–Lubricant Additives BusinessGrain in the Barn–Lubricant Additives BusinessJinzhou Kangtai focuses on the R&D, production, sales, and service of lubricant additives, offering one of the most comprehensive product portfolios in China.
-
 Grain in the Barn–Personal Care BusinessGrain in the Barn–Personal Care Business
Grain in the Barn–Personal Care BusinessGrain in the Barn–Personal Care BusinessAegis, a leading global supplier in UV protection, specializes in high-quality sunscreens, UV enhancers, antioxidants, and active ingredient solutions.
-
 Crops in the Field –Biomanufacturing BusinessCrops in the Field –Biomanufacturing Business
Crops in the Field –Biomanufacturing BusinessCrops in the Field –Biomanufacturing BusinessThe Life Sciences Division covers two industrial directions: building blocks and synthetic biology, which are both independent and highly synergistic in business logic and industrial relevance.
-
 Crops in the Field – New Materials such as Polyimide (PI)Crops in the Field – New Materials such as Polyimide (PI)
Crops in the Field – New Materials such as Polyimide (PI)Crops in the Field – New Materials such as Polyimide (PI)Yixing Chuangju Electronic Materials Co., Ltd., a top-tier supplier of advanced polyimide films, fills gaps in product and technology for domestic electronic-grade PI materials.
Delivering Anti-Aging Solutions Across Industries
Our products and technologies are widely used in various polymer materials,
making Rianlon one of the most comprehensive suppliers in the global polymer anti-aging industry.

-
agricultureagriculture
-
sports & recreationsports & recreation
-
home & personal carehome & personal care
-
fuels & lubricantsfuels & lubricants
-
household & toyshousehold & toys
-
electrical & electronicselectrical & electronics
-
fiber & textilefiber & textile
-
building & constructionbuilding & construction
-
Innovation & TechnologyInnovation & Technology
-
medical care & health caremedical care & health care
-
packagingpackaging
-
automotive & transportationautomotive & transportation
-
renewable energyrenewable energy
-
agricultureagriculture
-
sports & recreationsports & recreation
-
home & personal carehome & personal care
-
fuels & lubricantsfuels & lubricants
-
household & toyshousehold & toys
-
electrical & electronicselectrical & electronics
-
fiber & textilefiber & textile
-
building & constructionbuilding & construction
-
Innovation & TechnologyInnovation & Technology
-
medical care & health caremedical care & health care
-
packagingpackaging
-
automotive & transportationautomotive & transportation
-
renewable energyrenewable energy



We Offer a Full Range of Anti-Aging Additives
Enhancing Material Performance and Supporting Green Development

-
 Primary Antioxidants
Primary Antioxidants -
 Secondary Antioxidants
Secondary Antioxidants -
 UV Absorbers
UV Absorbers -
 HALS
HALS -
 U-pack
U-pack -
 Polymerization Inhibitors
Polymerization Inhibitors -
 Intermediates
Intermediates -
 Lubricant Additives
Lubricant Additives -
 Cosmetics
Cosmetics -
 Life Sciences
Life Sciences
From R&D to Supply
Comprehensively Safeguarding Your Anti-Aging Needs
Innovation-driven, achieving globally leading anti-aging solutions. Six production bases and a "dual-base production system with mutual backup" model ensure stable product quality and supply. A global distribution network provides efficient and rapid technical services.






From R&D to Supply
Comprehensively Safeguarding Your Anti-Aging Needs


-
20+government-certified R&D platforms
-
300+patents (as of December 2024)
-
60+countries where products are sold
-
36,000+ tonsof annual capacity in anti-aging additives
We Never Stop Exploring
-
 2025-08-25Ten Principles of the Global CompactNewsLearn More
2025-08-25Ten Principles of the Global CompactNewsLearn More -
 2025-08-25《高分子材料行业TCFD实施指南》NewsLearn More
2025-08-25《高分子材料行业TCFD实施指南》NewsLearn More -

 2025-09-17K Show 2025 | Join Rianlon in Düsseldorf to Discover Advancing Sustainable and High-Performance SolutionsNewsLearn More
2025-09-17K Show 2025 | Join Rianlon in Düsseldorf to Discover Advancing Sustainable and High-Performance SolutionsNewsLearn More -

 2025-09-02Malaysian Prime Minister Anwar Met with Li Haiping, Chairman and CEO of Rianlon CorporationNewsLearn More
2025-09-02Malaysian Prime Minister Anwar Met with Li Haiping, Chairman and CEO of Rianlon CorporationNewsLearn More -
 2025-08-25ISO 14090气候适应型材料NewsLearn More
2025-08-25ISO 14090气候适应型材料NewsLearn More -

 2025-04-24CHINAPLAS 2025 | Rianlon’s Anti-Aging Technologies Power Sustainable Growth in Rubber and PlasticsNewsLearn More
2025-04-24CHINAPLAS 2025 | Rianlon’s Anti-Aging Technologies Power Sustainable Growth in Rubber and PlasticsNewsLearn More -

 2025-04-07Resilience and Innovation: Rianlon Reflects on a Successful Participation at the European Coatings Show 2025NewsLearn More
2025-04-07Resilience and Innovation: Rianlon Reflects on a Successful Participation at the European Coatings Show 2025NewsLearn More -

 2025-04-03Join Rianlon at CHINAPLAS 2025 | Hall 15, Booth D41NewsLearn More
2025-04-03Join Rianlon at CHINAPLAS 2025 | Hall 15, Booth D41NewsLearn More -

 2025-02-17Discover Cutting-Edge Solutions with Rianlon at ECS 2025NewsLearn More
2025-02-17Discover Cutting-Edge Solutions with Rianlon at ECS 2025NewsLearn More -

 2024-12-19Rianlon Wins Kingfa's 2024"Outstanding Supplier" AwardNewsLearn More
2024-12-19Rianlon Wins Kingfa's 2024"Outstanding Supplier" AwardNewsLearn More -

 2024-12-10Rianlon Showcases Advanced Anti-Aging Solutions at CHINACOATNewsLearn More
2024-12-10Rianlon Showcases Advanced Anti-Aging Solutions at CHINACOATNewsLearn More -

 2024-12-09Rianlon Hosts Successful International Technical Seminars: Exploring Advanced Anti-Aging Strategies for Agricultural Films and Automotive MaterialsNewsLearn More
2024-12-09Rianlon Hosts Successful International Technical Seminars: Exploring Advanced Anti-Aging Strategies for Agricultural Films and Automotive MaterialsNewsLearn More -

 2024-11-22Join Rianlon at CHINACOAT 2024!NewsLearn More
2024-11-22Join Rianlon at CHINACOAT 2024!NewsLearn More -

 2024-10-25Innovative Solutions to Plastic Aging Challenges: Rianlon Shines at Fakuma 2024NewsLearn More
2024-10-25Innovative Solutions to Plastic Aging Challenges: Rianlon Shines at Fakuma 2024NewsLearn More -

 2024-09-09Rianlon Unveils Groundbreaking Anti-Aging Technologies at CTT 2024NewsLearn More
2024-09-09Rianlon Unveils Groundbreaking Anti-Aging Technologies at CTT 2024NewsLearn More